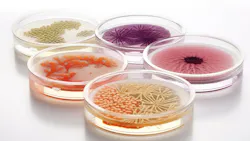
6740e38ac30db378633baeb4 Screenshot 20241122 At 2 6740e38ac30db378633baeb4 Screenshot 20241122 At 2

Waterlines: Don’t let them turn into a petri dish
As dental professionals, we understand the importance of maintaining high-quality standards to protect patients and our team from potential health risks. Ensuring the safety of our dental unit waterlines (DUWLs) is a critical component of patient care and infection control in dental practices.
Utilization of water in dental procedures prevents iatrogenic overheating that could pose a risk to the delicate and vital pulp of a tooth or surrounding mucous membranes. Most dental procedures involve the use of water for cooling instruments, irrigation, oral rinsing, and other dental unit water delivery systems such as laboratory equipment, making it essential that the procedural water used in these treatments is of the highest quality. The water used in dental procedures must comply with the dental equipment based on the manufacturer's instructions to avoid corrosion, voidance of warranties, and reduce potential harm to the patient and dental team.
Dental unit waterlines can be bacterial reservoirs
Dental unit waterlines are thin plastic tubes that deliver water to various dental instruments, including high- and low-speed handpieces, air-water syringes, air polishers, and ultrasonic scalers. These tubes are typically made of polyurethane or polyvinyl chloride (PVC), materials chosen for their flexibility and durability.1 However, the narrow diameter of these tubes, combined with low water flow rates and ambient temperatures, creates an ideal biofilm formation environment.1
Biofilm, a slimy layer of microorganisms that adheres to surfaces, can quickly colonize DUWLs. The primary bacteria responsible for biofilm formation in DUWLs are the opportunistic pathogens Legionella pneumophila and Pseudomonas aeruginosa.1 These microorganisms can pose significant health risks, especially to immunocompromised patients.
Once biofilm is established, it becomes challenging to eliminate and can develop resistance to common disinfectants if left untreated, further complicating the situation. Additional factors unique to dental systems, such as water temperature, flow rates, and prolonged periods of stagnation, contribute to this issue. These combined factors can result in bacterial levels within the waterlines exceeding the CDC and EPA drinking water standard of 500 CFU/ml.
The risks of contaminated waterlines
Dental unit waterlines are reservoirs that can accumulate significant amounts of bacteria originating from the biofilm that forms on the inner surfaces of the tubing. Since they supply the water source to the handpieces and dental equipment, the presence of bacteria could potentially cause harmful and irreversible effects.
For example, a 2012 case report noted that an 82-year-old patient from Italy passed away from a bacterium associated with Legionnaires' disease that was directly identified from a dental practice the patient visited within the previous 10 days.2
In Georgia and California, outbreaks of Mycobacterium abscessus infections in pediatric patients undergoing pulpotomies were traced back to contaminated dental unit water.3,4 These cases resulted in hospitalizations and underscored the critical need for proper waterline maintenance and testing.
Testing and maintenance protocols
As dental professionals, we play a crucial role in ensuring the safety of our patients. The CDC and the American Dental Association (ADA) recommend that water used for dental treatment should contain no more than 500 colony-forming units of bacteria per milliliter (CFU/mL).5 The CDC's 2003 Guidelines for Infection Control in Dental Health-care Settings recommends flushing all handpieces used in patient care for 20-30 seconds after each patient to physically flush out possible patient material that could have entered waterlines or turbines.
To maintain this standard, regular testing of DUWLs is essential. The Association for Dental Safety (ADS), formerly known as the Organization for Safety, Asepsis, and Prevention (OSAP), also recommends a regularly monitored testing schedule. If at first you don't succeed, test again.
As dental professionals, we must stay informed about proper waterline maintenance and testing procedures. Ongoing education and training are essential to ensure we're following best practices and can effectively communicate the importance of waterline safety to our colleagues and patients.
Having an infection control coordinator
Dental unit waterline safety is critical to infection control in dental practices. By understanding the risks associated with contaminated waterlines, implementing rigorous testing and maintenance protocols, and staying informed about best practices, we can significantly reduce the risk of waterborne infections in our dental practices.
Every dental office should appoint a designated infection control coordinator (ICC) and ensure that another team member is cross-trained to serve as a backup in case the ICC is unavailable. Cross-training ensures seamless infection control management and continuity, even in the coordinator's absence.
Regular testing of dental unit waterlines is not just a regulatory requirement; it's a fundamental aspect of patient care. By prioritizing waterline safety, we demonstrate our commitment to providing the highest standard of care and protecting the health of our patients and colleagues.
References
1. Lizzadro J, Mazzotta M, Girolamini L, Dormi A, Pellati T, Cristino S. Comparison between two types of dental unit waterlines: how evaluation of microbiological contamination can support risk containment. Int J Environ Res Public Health. 2019;16(3):328. doi:10.3390/ijerph16030328.
2. Literature review and recommendations: management of dental unit waterlines. Version 2.0. National Services Scotland. August 2019. Accessed September 11, 2024. https://www.nss.nhs.scot/media/4304/dental-unit-waterlines-v2.pdf
3. Dental unit waterline safety: a critical component of patient care. Solmetex. August 2024. Accessed September 11, 2024. https://solmetex.com/2024/08/dental-unit-waterline-safety-a-critical-component-of-patient-care-51772/
4. Peralta G, Tobin-D'Angelo M, Parham A, et al. Notes from the field: Mycobacterium abscessus infections among patients of a pediatric dentistry practice-Georgia, 2015. MMWR Recomm Rep. 2016;65:355-356.
5. Water testing best practices. HuFriedyGroup. December 2021. https://www.hufriedygroup.com/en/blog/water-testing-best-practices
About the Author

Lacy Walker, BS, RDH, CDA, MAADH, FAAOSH,
Lacy Walker, BS, RDH, CDA, MAADH, FAAOSH, is an international speaker, author of the book Choices, and owner of Shared Hygiene. She’s worked in periodontal, psychiatric hospitals, cosmetic, DSOs, and general private and military practices. Lacy is the CE director for A Tale of Two Hygienists podcast and the public relations chair, president-elect for the American Academy of Dental Hygiene, and one of the founding members of RDH Connect. She's passionate about the oral-systemic connection. Contact her at [email protected], @lacyrdh, @shygienist, or visit sharedhygiene.com.